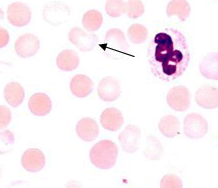
Choroba zimnych aglutynin w przebiegu zapalenia płuc u 15-letniej dziewczynki — opis przypadku

Publications
Peer-reviewed clinical case reports

Zarys problemu chorób rzadkich na podstawie omówienia serii przypadków pacjentów z chorobą Gauchera
An outline of the problem of rare diseases based on the presentation of case series of patients with Gaucher disease
Internal MedicineRare disease affects less than 1 person/2000 population. To date, 6,000 rare diseases have been detected. Each person is a carrier of 5-10 genes for rare diseases (mostly recessive genes). The rarity of of these diseases usually leads to a delay in making a correct diagnosis, sometimes by many years.
Choroba zimnych aglutynin w przebiegu zapalenia płuc u 15-letniej dziewczynki — opis przypadku
Cold agglutinin disease in the course of pneumonia in a 15-year old girl — Case Report
PediatricsMycoplasma pneumoniae is the agent eologiczny of 40% of out-of-hospital pneumonia in children. The infection most often involves the respiratory tract, some patients have symptoms from other organs and systems, including autoimmune hemolytic anemia with cold agglutinins.

Wspólne podłoże immunogenetyczne zapalenia części płaskiej ciała rzęskowego i stwardnienia rozsianego — opis przypadku
Common immunogenic background of pars planitis and multiple sclerosis — a case report
Internal MedicineMultiple sclerosis (MS) is the most common central nervous system (CNS) disease of unknown etiologii. There is a hypothesis of an interaction between the major tissue compatibility complex (HLA), activation of lymphocytes T lymphocytes and unknown factors initiating abnormal immune responses. An increased incidence of of uveitis in patients with MS, the most common form of which is inflammation of the part of the flat of the ciliary body (PP).

Złamanie zmęczeniowe panewki stawu biodrowego
Stress fracture of the acetabulum
SurgeryPelvic fatigue fractures most often involve the sacrum and hip bones. Their cause is repetitive micro-injuries to which people who engage in regular sustained physical activity are exposed. One of the rarest locations of a fatigue fracture is the acetabulum of the hip joint.

Chory z ciężkim niedożywieniem przed zastosowaniem obciążającego leczenia
Patients with severe malnutrition before aggressive medical treatment
OtherPatients with severe malnutrition make up a relatively small percentage of those qualified for surgery. Often the underlying pathology involves the gastrointestinal tract and is neoplastic in nature. Preparing patient for aggressive surgical and then oncologic treatment prior to surgery is particularly complex.

Chrzęstniakomięsak kości nadgarstka - opis przypadku
Chondrosarcoma of bones of wrist - a case report
SurgeryChondrosarcoma is a malignant neoplasm of the bone. It is the second most common among sarcomas of bones in adults. The early symptom is pain; in later stages, there is a tumor and distortion of the outline of the limb. The first and primary examination is a review roentgenography (X-ray) of the entire bone in two projections along with the adjacent joint. The histopathological diagnosis is established on the basis of an examination of the of tissue material taken during surgical biopsy. Treatment consists of resection of the tumor.

Trudności w różnicowaniu struktur błoniastych w obrębie prawego przedsionka
Difficulties in differentiation of membranous structures in the right atrium
SurgeryMembranous structures within the right atrium of the heart are a rare congenital defect that causes many diagnostic difficulties. In differentiation, we considered persistent sinus venosus valve, persistent Eustachian valve, persistent Tebezius valve, and persistent Chiari network.

Niedrożność mechaniczna jelita grubego w przebiegu endometriozy - opis przypadku
Mechanical ileus of large bowel in course of endometriosis - a case report
SurgeryEndometriosis is a disease in which endometrial cells are located outside the uterine cavity. It affects women of reproductive age reproductive age. Rarely, endometriosis foci localize in the gastrointestinal tract. Intestinal endometriosis most often occurs in the large intestine, sometimes causing mechanical obstruction.

Przypadek ephysematosus pyelonephritis u pacjentki z cukrzycą
A case of emphysematous pyelonephritis in diabetic patient
SurgeryEmphysematous pyelonephris (EPN) is an acute complication of urinary tract infection with bacteria that produce gas. The mortality rate in this condition, according to some authors, can be as high as 80%. The most common pathogen causing EPN is Escherichia coli. Therapy is based on empirical administration of antibiotics and surgical treatment.

Specyfika zakażenia wirusem brodawczaka ludzkiego z obecną utajoną postacią toksoplazmozy i zakażeniem wirusem Epsteina-Barr u kobiet, które poroniły
Features of papiloma viral infection at unmaturing of pregnancy for women with latent toxoplasmosis in association with EBV-infection
GynecologyThe study included 72 women who had miscarriages and were diagnosed with the latent form of toxoplasmosis in combination with with human papillomavirus (HPV) and Epstein-Barr virus (EBV) infection. The study found was the absence of clinical signs of infection with positive polymerase chain reaction (PCR) results for the presence of HPV and EBV genetic material. The latent form of HPV infection in combination with EBV infection and toxoplasmosis is more often characterized by a high levels of HPV types: 16, 31, 35, 52, 56, 58, 59 in the urogenital smear, low IgG avidity to T. gondii and a high content of ЕBV in saliva. Only 2 of the 72 women tested had spontaneous regression of HPV within a year. In order to reliably predict oncogenic risk and exclude manifest infection, long-term prospective follow-up. In order to determine the exact cause of miscarriages in women with latent toxoplasmosis combined with infection- EBV and HPV infection, it is necessary to use PCR testing from stillbirth tissues.

Przygotowanie żywieniowe do operacji z powodu choroby nienowotworowej przed przyjęciem do szpitala
Nutritional support before surgical procedure in non-cancer patients
OtherAmong patients qualified for surgery, especially with gastrointestinal pathology, the percentage of malnourished reaches 60%. Preparation of the patient before surgery should be comprehensive and include optimization of nutritional status.

Udar niedokrwienny mózgu spowodowany zatorem płynem owodniowym - opis przypadku
Ischaemic stroke caused by the amniotic fluid embolism (AFE) - a case report
Internal MedicineAmniotic fluid embolism (AME) is a rare complication of pregnancy, unpredictable, with a varied clinical picture clinical picture, with dangerous consequences for mother and newborn. PE is the cause of 20% of perinatal maternal deaths [1]. Embolism is caused by amniotic fluid entering the mother's circulation. The authors of describe the case of a 21-year-old female patient who was diagnosed with amniotic fluid embolism. The newborn, who was born at 35 weeks' gestation, by natural means with a birth weight of 2620 g, with APGAR scores: 0-2-5-6-7 points at 1-3-5-10-15 minutes of life respectively, with symptoms of perinatal hypoxia, survived. His mother suffered a severe complication of ischemic stroke with hemiplegia.